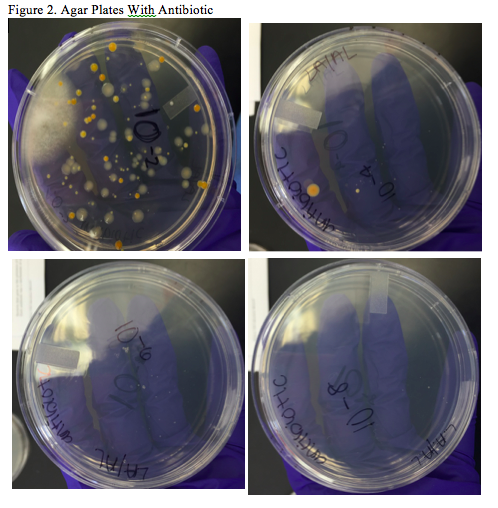
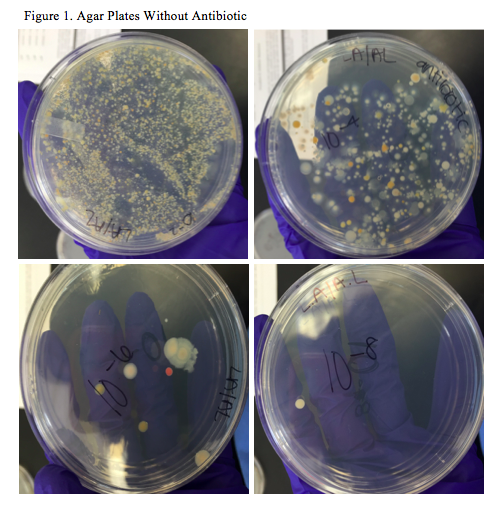

User:Andrea Lopez/Notebook/Biology 210 at AU
1/24/2015 Transect Observations
Biotic - ants - vegetable plants - worms - tree - grass
Abiotic - soil - wood chips - bark - rocks - water
Our transect included various vegetable plants such as carrots, lettuce, onions, and more; however, some of the plant leaves appeared to be dead possibly by the cold and frigid weather. In addition, there was a pipe running through the entire transect to water the growing plants. There was also an enormous pine tree in the back of the transect which left many pine needles on the floor. The soil in our transect was extremely moist possibly due to the fact that the plants were watered and taken good care of.
1/21/2015 Hay Infusion Culture Observations
Purpose The purpose of this lab was to examine and observe which organisms were present in our transect. By determining and identifying the differentiating organisms, we will be able to further analyze the content and environment our transect holds. In addition, further information about the organisms within the transect gives us a depend knowledge on eukaryotic and prokaryotic organisms and their preferred environment.
Materials and Methods To begin our observations, we took a drop of each niche within our hay infusion and placed it on a microscope slide. After that was done, a cover slip was placed over the sample. We then began our observations by placing the slide on the microscope and closely examining the various organisms that were found. To correctly determine the type of organism, we used a dichotomous key. To prepare for next week's lab, four tubes of 10mLs containing broth were labeled. Next, eight agar plates were attained to begin the plating (one containing antibiotics and one not). 100 microliters of the content within the hay infusion were added to the 10 mLs of broth. 100 microliters of the previous tube were then added to the next tube labeled 10^-4. This process was repeated to complete the next two dilutions. Once the solutions were prepared, a micropipette dispensed 100 microliters of the culture into the agar plate and spread with an inoculating tube. This procedure was then repeated with each tube so all eight agar plates contained a sample of each diluted solution.
Data and Conclusions The two niches identified within the hay infusion varied to a high extent. The bottom niche contained materials that were more dense such as soil, rocks, and some heavy leaves. In the top niche, a film of green mold covered the entire liquid. Perhaps the reason why the top niche did not contain plant material is because it is not dependent on plant features. In addition, mold grows at best capacity under airy conditions which could explain why there was mold closer to the surface of the container. Because the mold was at the top of the container, the smell of the content appeared to be a mixture of dirty sewage water and fertilizer. By observing the culture from both niches, we found that many of the organisms were motile. The organisms found in the top niche were Volvox, Blepharisma seculum, Euplotes patella and , Oscillatoria curviceps. Out of those four, all of them displayed a form of motility. Volvox displayed a rolling motion despite of the non-motile gonidia in the interior of the organism. Blepharisma moved by organisms specializing in motility. In addition, the organism contains cilia to assist in movement. Euplotes patella have a swimming-like feature and were extremely difficult to observe due to their fast movement. Lastly, the Oscillatoria curviceps moved by means of their microfibrils. In the bottom niche, we found Colpidium campylum and Nostoc azollae. Nostoc azollae moved by relatively short motile filaments called harmogonia whereas Colpidium did not display any motile features. By utilizing the Dichotomous Key, we found that Volvox, Oscillatoria curviceps and, Nostoc azollae all perform photosynthesis. More specifically, Nostocs perform photosynthesis by photosynthetic pigments contained in the cytoplasm. Volvox and Oscillatoria are common in the fact that they are both algae. The rest of the organisms seemed to obtain nutrients by means of specialized organelles such as vacuoles. Volvox displayed all five features that identify a living organism. Firstly, volvox use and receive their energy through photosynthesizing mechanisms. Their DNA is replicated during cleavage and is composed of numerous cells. Volvox is unique in that it can reproduce both asexually and sexually. Lastly, Volvox continues to evolve within each differentiating habitat. It can be predicted that in two months, the ecosystem within the Hay Infusion Culture will continue to grow due to the organism's individual mechanisms. For example, a symbiotic relationship between organisms will allow the ecosystem to continue to grow or obtain stability.
Organisms Found in Hay Infusion Culture
1/28/2015 Identifying Bacteria from Prepared Agar Plates
Purpose For this lab, the purpose was to identify the bacteria on the agar plates using gram stain and microscopes. Characteristics we were looking at included cell morphology, motility, and the type of gram stain. These observations allowed further entail in what our transect entailed and which bacteria grow best in that type of environment.
Materials and Methods To begin the lab procedure, observations of the Hay Infusion Culture were taken to note any changes that may have occurred. After observations were noted, observations of the agar plates inoculated from the Hay Infusion Culture were taken. We carefully counted the number of colonies on each plate and noted it on the spreadsheet. Four small samples of a chosen colony from the agar plates were taken using a toothpick to place on the microscope slide on top of the drop of water. Using the microscope, one was able to determine cell morphology and motility. Afterwards, another four samples from the same bacterial colonies were placed on a microscope slide using a sterilized inoculating tube to begin the gram staining process. After rinsing the sample with crystal violet, water, iodine, water again, and 95% alcohol, the microscope slide was placed on the stage of a microscope to begin observations on whether the bacteria was gram negative or positive. To prepare for next week's lab, one sample from each of the two plates that had the most characterization were taken. 20 microliters of primer were added to each PCR tube and then mixed. The samples of bacteria were then added to the tubes and mixed with a toothpick. Finally, the complete PCR tube was placed in the PCR machine.
Data and Conclusions The hypothesis which stated that if the samples of bacteria were motile then the gram stain would be positive was supported by the data collected. The two bacteria samples that were taken from the plates without the antibiotic displayed motility. In the plate that was diluted to 10^-4, the bacteria were coccus-shaped, extremely minuscule, and green. Even though the motility was not as apparent compared to the motility in the 10^-6 plate without antibiotic, it could have been described as a slow, rolling motion. The bacteria observed in the other plate displayed obvious movement as it displayed a rapid, swimming-like motion. The other two samples observed did not display any sort of motility and remained stationary. The two samples did not display motility possibly because they were taken from the plate that contained the antibiotic. It could have been that the antibiotic had ceased the bacteria's ability to move. When the gram stain procedure was finished, our data showed that the two bacteria which displayed motility were gram positive. It is unclear if the motility of the cell has an effect on the characteristic of gram positive but, the data collected displayed this particular pattern. The other two bacteria cells that remained stationary were gram negative. This observation supported the hypothesis despite if there is an apparent reasoning behind the pattern noted. Observations of the colonies within the plates showed that the plates without the antibiotic contained a more significant bacteria growth than the plates without. This could be because the antibiotic served as it should and ceased the growth; however, some bacteria did grow in the plates with the antibiotic. The bacteria that grew with the antibiotic can be said that they are antibiotic-resistant. This could be potentially harmful and cautioning as more and more bacteria obtain resistance. Additionally, the plates without the antibiotic displayed darker colors of bacteria colonies such as dark reds and oranges.
2/4/16 Observing and Determining Plant Characteristics
Purpose The purpose of this lab was to determine certain characteristics of the plants we found within our transect. Through careful observations, we were able to determine plant vascularization, mechanisms of reproduction, and specialized structures. Unveiling plant characteristics allowed us to further understand how the plants within our transect reproduce and grow.
Materials and Methods To begin our observations we obtained two gallon-sized ziploc baggies and filled one bag with live plant matter and the other with what appeared to be dead plant matter. We then took five samples of live plant matter to determine vascularization, specialized structures, and mechanisms of reproduction. To determine these characteristics, we not only looked at the plant matter with the naked eye but, using a razor, we carefully cut off a small segment of the root and placed it inside a depression slide. The sample was then placed under the microscope to begin further observations. To find out the form of vascularization of our plants, we looked at the bottom of the leaf/plant matter to take a closer look at its roots and branching veins. Most of this weeks consisted of observations but, to prepare for next week's lab, a berlese funnel was set up to collect invertebrates. To begin, 25 mL of 50:50 ethanol/water solution was poured into a 50mL conical tube. A small piece of screening material was taped to the bottom of the funnel to keep leaves out of the preservative. Leaf litter was then placed in the top of the funnel. The conical tube was then secured with parafilm to the bottom of the funnel. Once the funnel was set up, it was attached to a ring stand under a 40 watt lamp 1-2 inches from the top of the leaf litter.
Data and Conclusions Based by our observations, we learned that all of our plants are dicots. Dicots can be characterized by having an embryo with two cotyledons whereas monocots only have an embryo with a single cotyledon. Another big difference between monocots and dicots is that the veins are reticulated through the leaf while monocots veins run parallel to one another. In addition, we found the plant mechanisms of reproduction to be a mixture of gymnosperms and amniosperms. Gymnosperms are vascular plants that reproduce by means of a seed or ovule. Unlike angiosperms
Figure 1. Sample Plant Pictures
Table 1. Characteristics of Plants Collected from the Transect
2/11/16 - Identifying Invertebrates from Transect 5
Purpose The purpose of this lab was to identify and characterize the invertebrates found from transect 5. By identifying the invertebrates, we receive a depend understanding of the ecosystem the transect consists of. In addition, we are able to understand the importance of invertebrates have on the ecosystem.
Materials and Methods To begin the lab, we began by observing the coelomate, Planaria, using a dissecting scope. Following Planaria, we observed the nematodes and the coelomate Annelida. After observations were taken from the Coelomates, Pseudocoelomates, and Coelomates, we obtained samples from our Berlese Funnel to observe and characterize the invertebrates that were found in the transect. To begin this procedure, the Berlese Funnel was carefully taken apart. Then, 10-15 mL of 50% ethanol and organisms were poured into a petri dish. The remaining of the sample was then poured into a second petri dish. Observations of the invertebrates were then taken by examining the two petri dishes under a dissecting microscope.
Data and Conclusions From observing the organisms found within our funnel sample, we learned that the majority of the invertebrates are from the Phylum Anthropoda and Class Insecta with one exception. The Class Insecta from Phylum Arthropoda are one of the most primitive organisms within almost every ecosystem. These organisms were found in our transect most likely due to the simple fact that they are the organisms that are most commonly found within a wide range of ecosystems. The first sample taken from the funnel consisted of all Class Insecta invertebrates, whereas the sample that contained the remaining of the contents had one organism that was Class Diplopoda from Phylum Anthropoda. This organism was most likely found in the remaining of the sample because it is most commonly found in environments that contain soil. The first sample contained organisms that are most likely to found on leaves. In addition, we observed that the organisms found in the first sample all contained at least four legs and antennae. In the second sample, the organism had multiple legs (more than 10) and had one long body segment. From the observations and data collected, one can conclude that organisms within Class Anthropoda and Class Diplopoda are primitive organisms that are needed for the ecosystem within the transect to be sustainable. While this lab focused primarily on invertebrates, one can use that information to make predictions about vertebrates that might be present in the transect. Five vertebrates that might inhabit the transect are squirrels, opossums, finches, sparrows, and rabbits. Squirrels are from Phylum Chordata, Class Mammalia, Order Rodenti, Family Sciuridae, Genus Sciurus, and Species Sciurus carolinensis . Opossums are from Phylum Chordata, Class Mammalia, Order Didelphimorphia, Family Didelphidae, and Species Didelphis virginiana. Finches are from Phylum Chordata, Class Aves, Order Passeriformes, Family Fringillidae, and Species Fringilla coelebs. Sparrows are from Phylum Chordata, Class Aves, Order Passeriformes, Family Passeridae, and Species Passer domesticus. Rabbits are from Phylum Chordata, Class Mammalia, Order Lagomorpha, Family Leporidae, and Species Lepus californicus altamirae. An abiotic characteristic that would benefit each of the species is water. Since each of these organisms require water to survive, they would benefit immensely from the water present in the transect. In addition, the organisms in Class Aves would benefit from soil and broken branches to build habitats. A biotic factor that would benefit each of the organism are the vegetables grown in the transect. Class Aves would benefit from certain invertebrates present in the transect. These organisms represent the ecological concepts of community because they are all represent a diverse and are abundant in species. Carrying capacity, the number of living organisms, or crops that a region can support without environmental degradation, is represented in the ecosystem of the transect. Each organism benefits from one another in some way. Photosynthetic plants complete the first level of trophic levels. Because the transect is rich in plants, nutrient recourses are easily distributed within the ecosystem.
2/18/2016 - Setting up Zebra Fish Development in Response to Nicotine Experiment
Purpose The purpose of this lab was to begin the experiment in examining the effects of nicotine in zebra fish development.
2/25/2016 - PCR sequence MB47-For_16S_G06.ab1 NNNNNNNNNNNNNNNNNCTNNNCNTGCAGCCGAGCGGTAGAGATTCTTCGGAATCTTGAGAGCGGCGCACGGGTGCGGAA CACGTGTGCAACCTGCCTTTATCAGGGGAATAGCCTTTCGAAAGGAAGATTAATGCCCCATAATATATCATATGGCATCA TTTGATATTGAAAACTCCGGTGGATAAAGATGGGCACGCGCAGGATTAGATAGTTGGTAGGGTAACGGCCTACCAAGTCA GCGATCCTTAGGGGGCCTGAGAGGGTGATCCCCCACACTGGTACTGAGACACGGACCAGACTCCTACGGGAGGCAGCAGT GAGGAATATTGGACAATGGGTGAGAGCCTGATCCAGCCATCCCGCGTGAAGGACGACGGCCCTATGGGTTGTAAACTTCT TTTGTATAGGGATAAACCTACCCTCGTGAGGGTAGCTGAAGGTACTATACGAATAAGCACCGGCTAACTCCGTGCCAGCA GCCGCGGTAATACGGAGGGTGCAAGCGTTATCCGGATTTATTGGGTTTAAAGGGTCCGTANGCTGATGTGTAANTCANTG GTGAAATCTCACANCTTANCTGTGAAACTGCCNTTGATACTGCATGTCTTGAGTGTTGTTGAANTANCTGGAATAANTNN GTANCAGTGAAATGCCTANATATTACTTNNANCACNANGTGCTAANGCANGTTGGTANNCCNCNACTGACNCTGATNGAG NAAANCNTGGGNNAGCGAACANAANTNNATACCCTGGGGNNGTNNNCNNNAANNAANCTNANTCNNTTTTTNTCTTTCTC TTNCNNATACANNNNNANCCGANAAGNTNGCCNNCTNCCGGGTGGTGTTCTCCNTNNTNNNGATGNNNTCNNCTNNNNNN NNNNNCNGCCCCCCCNCAANNATTTNTANANNNNTATANNNTNNNANANCNNGCGGCCCCCTNTNTAANNGGNNNNGGGG GAGNNNNNNGNNNNNGTTTTCTATTATATNTNNNNCTNTNNNCCNCNNGNNCNGGGGGGGTTGTNTCTCCCNNCCAGAAC NNAANGANANTNTNCNNCANCAGCCNNNN
MB48-For_16S_H06.ab1 NNNNNNNNNNNNNNGCNNANNNTGNNANNNNNGCGGTANGANGGGANGCTTGCTCTNNGATTCAGCGGCGGACGGGTGAG TAATGCCTAGGAATCTGCCTGGTAGTGGGGGACAACGTTTCGAAAGGAACGCTAATACCGCATACGTCCTACGGGAGAAA GCAGGGGACCTTCGGGCCTTGCGCTATCAGATGAGCCTAGGTCGGATTAGCTAGTTGGTGAGGTAATGGCTCACCAAGGC GACGATCCGTAACTGGTCTGAGAGGATGATCAGTCACACTGGAACTGAGACACGGTCCAGACTCCTACGGGAGGCAGCAG TGGGGAATATTGGACAATGGGCGAAAGCCTGATCCAGCCATGCCGCGTGTGTGAAGAAGGTCTTCGGATTGTAAAGCACT TTAAGTTGGGAGGAAGGGCATTAACCTAATACCTTGGTGTTTTGACGTTACCGACAGAATAAGCACCGGCTAACTCTGTG CCAGCAGCCGCGGTAATACAGAGGGTGCAAGCGTTAATCGGAATTACTGGGCGTAAAGCGCGCGTANGTGGTTTGTTAAG TTGGATGTGAAAGCCCCGGGCTCAACCTGGGAACTGCNTTCNAAACTGNCNAGCTAGAGTATGGTANAGGGTGGTGGAAT TTCCTGTGTAGCNNTGAAATGCGTAGATATANGAANGAACACNNNGTGGCNAAGCGGACCACCTGNACTGATACTNACAC TGANNTGCGAAANNNTGTGGANCAAACANNATTANGATNNCCTNNAGTCCACNGCCNGTANACNNNNTCAACTANCNNNN NNAGCNCTTNANNTGTTANTGNCGCNNCTAACNCATTAANTNNCNNCGCTGGNTNNGTAGNAGNCCNCGNCCGTTAGNNC TNNNNNNGGAGTTNANNGGNGCCNNGCACAAGCNACTGNAGCAGGGNGGGNTGTAGTTCCNAANNNNNNACNAAAAANNN NNACCCNGNCCCTNGGNATNNAANNNAGNNNNNGAGGNNNNNNAANNNGNGNNNNGGNTGNNNNCNNNGGAAANNNNACC ANNNGNNNATGGTNGGNNNNNNNCNNCANNNNNNCNANCCCNNNNNNN
ZebraFish Developmental Effects Caused by Nicotine Exposure - March 1, 2016
Purpose The purpose of this experiment as a whole was to examine the effects of nicotine on zebrafish development.
Materials and Methods To begin examining the effects of nicotine on the development of zebra fish, 24-hour zebra fish embryos had to be selected carefully using a pipette. The embryos that were selected were ones that appeared to be healthy and living. Embryos that seemed to be cloudy were avoided as that indicated that they were no longer living. The single embryo was then placed in an individual well. A pipette was used in some instances if access water entered the well to derive it. Two containers each containing 24 individual wells were separately labeled “Treatment” and “Control.” Once the two containers were filled with 48 embryos in total, the content of the variable and control group was added. For the treatment group, 2mL of water containing nicotine was added into the individual wells. To ensure that the concentration of nicotine was low enough to not die off the treated fish, but high enough to see effects, scholarly articles were reviewed to determine the adequate nicotine concentration. The concentration of the nicotine water used was 4.0g/mL. Only 2mL of distilled water was added to the control group. Initial observations were taken using a dissecting microscope and the two containers were topped with their lids. As the study proceeded, different observations were noted such as heart rate, length of fish, the amount of fish alive, and fish startle response. To account for length, a ruler was used to measure the fish in centimeters. To measure the heart rate, the beats seen were counted in a 10 second time frame. The amount of beats seen in the ten seconds were then multiplied by 6 to translate the amount to beats per minute (BPM). The amount of fish that survived were counted carefully under a dissecting microscope. Fish that appeared to have a white substance covering them or that seemingly appeared absent from their wells were considered dead. The startle response seen in the fish were observed by flicking the outside of the well. In order to ensure the optimal health of the fish, the fish were cared for on a daily basis with the exception of weekends. Once the fish seemed to have hatched and no longer contained a yolk sac, 50 microliters of shrimp solution were fed to the fish. In addition, the wells that appeared to have dried up were taken care of by refilling them with the appropriate content. The fish were placed under normal room temperature and kept away from extreme lighting.
Results Results indicated that as the study proceeded, the length of the zebra fished increased steadily starting from 0.8 cm and ending in 2.1 cm. There was, however, a sudden increase on the second day that could have resulted from an error (Table 1). In addition, results derived from observations showed that the amount of fish alive decreased in both the control and treatment group. The fish treated with nicotine died off quicker than the control fish (Table 2). The startle responses in the treatment group observed from the study were not as uniform or natural as the startle responses seen in the untreated fish (Table 3). The heart rate measured in the treatment group differed significantly from the control group. The heart rate in the treated fish was higher than the heart rate observed in the control group (Table 4).
Discussion The hypothesis that stated that if zebrafish were to be exposed to nicotine, then heart rate, overall survival rate, and startle response will differ significantly between the control and treatment group was supported by the data collected. The heart rate observed in the treatment group was significantly higher than the heart rate observed in the control group (Figure 3). The increased heart rate seen in the group treated with nicotine was caused primarily by the stimulation of sympathetic neurotransmission. Catecholamine, a hormone produced by the adrenal glands, is effected specifically by nicotine from stimulating the release of the hormone. The activation of nicotine acetylcholine receptors allows for the hormone to bind to its binding site. This in turn changes the shape of its central pore resulting in a rush of calcium and sodium ions. The influx of sodium and calcium ions then causes the heart rate to increase above its normal rate (Haass & Kubler, 1997). The overall survival rate of the zebrafish treated with nicotine was considerably lower than the zebrafish that were left untreated. This observation could have resulted for numerous reasons. Nicotine poisoning could have been a reason as to why zebrafish exposed to nicotine died off rapidly. Nicotine poisoning is lethal due to excessive stimulation of nicotinic cholinergic neurons. Nicotine is an agonist for nicotinic acetylcholine receptors which are centered in the central and autonomic nervous systems as well as the neuromuscular junction. Low doses of nicotine simulate these receptors; however, high doses or more can lead to inhibitory effects leading to neuromuscular blockade. Neuromuscular blockade then causes paralysis of the affected skeletal muscles. Neuromuscular blockade can perhaps be a reason behind the differences in startle response between treated and nontreated fish (Horan, et al., 1977). The nontreated fish showed a natural startle response where when inflicted with a tapping outside the well, the fish moved or startled away to a different location within the well. The treated fish however, did not have a uniform startle response where a stimulus caused them to move. Instead, they simply displayed sporadic movements in which they appeared to be twitching. The fish treated with nicotine were unable to move in their natural way post likely due to neuromuscular blockade (Table 3). Survival rates in the fish treated with nicotine were possibly lower due to nicotine’s altering powers on the trajectory of neurodevelopment. Defects continue to emerge over the life span of a fetus, such as long-term alterations in synaptic function. This means that there is likely to be a biological basis for increased susceptibility to nicotine dependence and long-term, adverse consequences during this developmental stage. These adverse effects in turn could have been lethal to the zebrafish (Arneric & Brioni, 1999). Multiple errors were encountered when determining the effects of nicotine on zebra fish development. One error that was made was that the zebrafish were not fed on one of the days of observations. This could have leaded to a quicker death since the zebrafish were not receiving the appropriate nutrition. Because zebrafish learn how to eat while in the embryo, it was imperative to expose them to food so they would be able to learn how to eat in further stages of development. Since the zebrafish were not exposed to food early on, they were possibly not able to eat the food that was given to them. Another error encountered was that the environment surrounding the zebrafish was not as controlled as it could have been. For example, the fish were placed in a different spot of the lab on some of the days observations were taken. On other days, the lab was warmer than usual and could have effected the zebrafish. To improve the study in the future, the zebrafish could have be closely monitored by taking observations every day including weekends. In addition, one must attempt to keep the fish alive long enough for them to be fully grown. This would create further insight on the true defects of nicotine on zebrafish development.